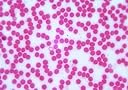
Thumbnail 4

Buy anything from 5,000+ international stores. One checkout price. No surprise fees. Join 2M+ shoppers on Desertcart.
Desertcart purchases this item on your behalf and handles shipping, customs, and support to Denmark.
This set of 10 slides includes a Head Louse, a Tapeworm and a Tick, Human Cheek Cells, Human Blood and Human Skin. Strepto Coccus, Tuberculosis, Pinworm and a Bacteria Smear.
Trustpilot
1 month ago
4 days ago
2 weeks ago
1 month ago